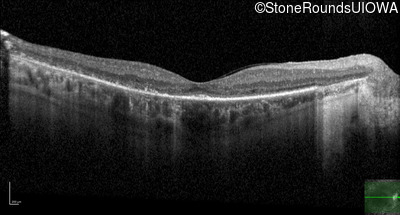
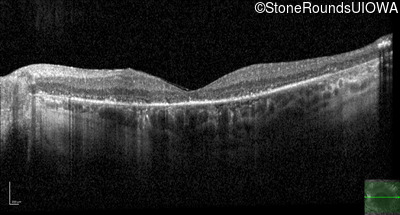
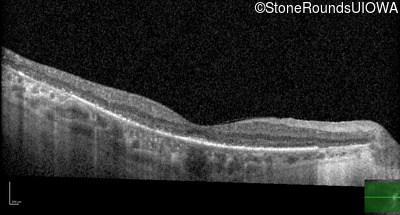
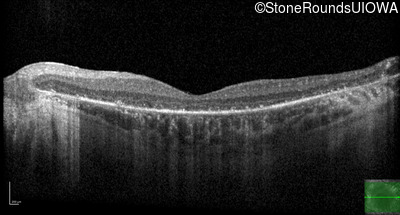

Case
SR2634
Student Mode
AD Retinitis Pigmentosa (IA1aii)
Female
Female
Hidden
SR2634
Student Mode
AD Retinitis Pigmentosa (IA1aii)
Female
Female
History
This 59 year old woman has been night blind for as long as she can remember. She first noted constricted visual fields in her late 30s.
| Age at visit: 59 years |
Diagnosis & molecular findings
| Disease | Gene | Allele 1 variant(s) | Allele 2 variant(s) | Inheritance mode |
|---|---|---|---|---|
| AD Retinitis Pigmentosa | RHO | Glu181Lys GAG>AAG | AD |